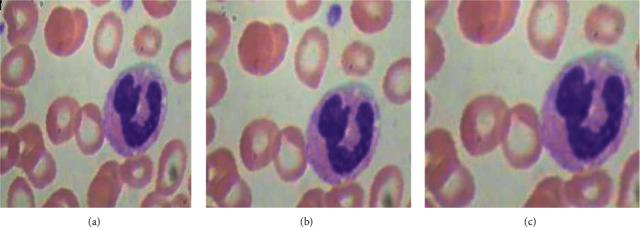
https://cdn.ncbi.nlm.nih.gov/pmc/blobs/9439/8769872/4de968b3ea86/CIN2022-7384131.005.jpg

深度学习模型在白细胞自动分类中的应用。
Deep Learning Model for the Automatic Classification of White Blood Cells.
机构信息
Chitkara University Institute of Engineering and Technology, Chitkara University, Chandigarh, Punjab, India.
KIET Group of Institutions, Delhi NCR, Ghaziabad, India.
出版信息
Comput Intell Neurosci. 2022 Jan 12;2022:7384131. doi: 10.1155/2022/7384131. eCollection 2022.
Blood cell count is highly useful in identifying the occurrence of a particular disease or ailment. To successfully measure the blood cell count, sophisticated equipment that makes use of invasive methods to acquire the blood cell slides or images is utilized. These blood cell images are subjected to various data analyzing techniques that count and classify the different types of blood cells. Nowadays, deep learning-based methods are in practice to analyze the data. These methods are less time-consuming and require less sophisticated equipment. This paper implements a deep learning (D.L) model that uses the DenseNet121 model to classify the different types of white blood cells (WBC). The DenseNet121 model is optimized with the preprocessing techniques of normalization and data augmentation. This model yielded an accuracy of 98.84%, a precision of 99.33%, a sensitivity of 98.85%, and a specificity of 99.61%. The proposed model is simulated with four batch sizes (BS) along with the Adam optimizer and 10 epochs. It is concluded from the results that the DenseNet121 model has outperformed with batch size 8 as compared to other batch sizes. The dataset has been taken from the Kaggle having 12,444 images with the images of 3120 eosinophils, 3103 lymphocytes, 3098 monocytes, and 3123 neutrophils. With such results, these models could be utilized for developing clinically useful solutions that are able to detect WBC in blood cell images.
血细胞计数在识别特定疾病或病症的发生方面非常有用。为了成功测量血细胞计数,需要使用利用侵入性方法获取血球幻灯片或图像的复杂设备。这些血球图像会经过各种数据分析技术,对不同类型的血球进行计数和分类。如今,基于深度学习的方法已被用于分析数据。这些方法耗时更少,所需的设备也不那么复杂。本文实现了一个深度学习 (D.L) 模型,该模型使用 DenseNet121 模型对不同类型的白细胞 (WBC) 进行分类。DenseNet121 模型经过归一化和数据增强预处理技术进行了优化。该模型的准确率为 98.84%,精度为 99.33%,敏感性为 98.85%,特异性为 99.61%。该模型使用四个批量大小 (BS) 以及 Adam 优化器和 10 个时期进行了模拟。结果表明,与其他批量大小相比,DenseNet121 模型在批量大小为 8 时表现更好。该数据集来自 Kaggle,其中包含 12444 张图像,其中有 3120 个嗜酸性粒细胞、3103 个淋巴细胞、3098 个单核细胞和 3123 个中性粒细胞。有了这些结果,这些模型可以用于开发临床上有用的解决方案,能够在血球图像中检测白细胞。